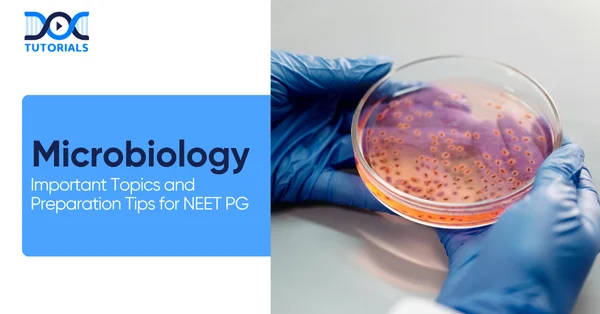
Microbiology in NEET PG

Microbiology: Important Topics and Preparation Tips for NEET PG
Microbiology is arguably the most demanding subject of study for NEET PG preparation. It is the basis on which infectious diseases, laboratory diagnosis, and antimicrobial drugs are established, all critical for both exam success and clinical practice. Despite having a vast syllabus, it is also one of the highest-scoring subjects in the medical PG entrance exams.
According to the present NEET PG subject-wise marks distribution, there will be around 20 multiple-choice questions (MCQs) based on this subject. It carries significant weight, making it important for students who want a high rank.
In this article, we will be discussing these most critical topics together with practical preparation tips to guide you strategically and confidently prepare for Microbiology for the NEET PG exam. Keep reading for a detailed insight.
What are the Most Critical Topics of Microbiology for NEET-PG?
Below is a unit-wise compilation of the Microbiology critical topics:
- General Microbiology
- History
- Staining Techniques
- Culture Media
- Sterilisation Techniques
- Bacterial Cell Wall
- Bacterial Growth Curve
- Bacteriology
- Staph, Streptococcus, Corynebacterium, Bacillus, Clostridium
- Enterococcus Family
- Mycobacterium
- Pseudomans, Haemophilus, Brucella, Bordetella, Yersinia
- Vibrio
- Chlamydia
- Rickettsia
- Mycoplasma
- Helicobacter, Campylobacter
- Listeria, Legionella
- Neisseria
- Virology
- General properties of a virus
- Herpes
- Pox
- Rabies
- Polio
- Adenovirus
- Hepatitis
- HIV (Human Immunodeficiency Virus)
- Influenza
- Dengue
- Mycology
- General properties
- Dermatomycosis
- Dimorphic fungi (special points of each)
- Aspergillus
- Candida
- Cryptococcus
- Parasitology
- Entamoeba
- Giardia
- Plasmodium
- Leishmaniasis
- Solium
- Nana
- Ascaris
- Wuchereria (Image)
- Schistosomiasis
- Images of Eggs of all Parasites
- Immunology
- Antigen
- Antibody
- Reaction Between Antigen and Antibody (Examples)
- Hypersensitivity Reaction (Examples)
- GVHD (Graft-versus-host disease)
- Autoimmunity
Other Important Microbiology Topics for NEET PG 2026
Here’s a list of a few more detailed topics that are essential for NEET PG 2026:
Scientists and Stains
- Louis Pasteur
- Robert Koch
- Paul Ehrlich
- Fixation
- Simple Stains
- Negative Stains
- Impregnation Stains
- Differential Stains
- Flagella Stains
- Spore Stain
Microscopes
- Features of Microscopes
- Light Microscope
- Dark Field Microscope
- Interference Contrast Microscope
- Fluorescence Microscope
- Phase Contrast Microscope
- Electron Microscope
- Differences between Electron and Light Microscopes
Bacterial Anatomy
- Capsule Layer
- Slime Layer
- Capsule and Slime Layer
- Demonstration of the capsule
- Modification of slime: Biofilm
- Cell Wall Basics
- Endotoxins vs Exotoxins
- Cell wall-deficient forms – L form
- Bacterial Anatomy
- Structure of flagella
- Demonstration of motility
- Spores
- Spore formation
- Stains
- Difference: Prokaryotes vs. Eukaryotes
Bacterial Shapes And Physiology
- Bacterial Shapes (Cocci)
- Bacterial Shapes (Bacilli)
- Bacterial Physiology
- Quick Definitions: Bacterial Physiology
- Bacterial Growth Curve
Bacterial Genetics
- Basics
- Mutations
- Point Mutations
- Frame Shift mutation
- Gene Transfer
- Transformation
- Transduction
- Bacteriophage Cycle
- Generalised Transduction
- Specialised/ Restricted Transduction
- Conjugation
- Plasmids
Culture Media
- History
- Agar
- Simple Media / Basal Medium / Basic Medium
- Enriched Media
- Selective Media
- Differential media
- Transport Media
- Anaerobic Media
- Anaerobic methods
- Anaerobic methods
- Culture Technologies
- Antibiotic Sensitivity Testing
- Dilution method
- Disc Diffusion Method or Kirby-Bauer Disc Diffusion Method
- Stoke’s Disc Diffusion Method
- Epsilometer Test
Sterilisation and Disinfection
- Sterilisation Methods
- Dry heat
- Incineration
- Hot Air Oven
- Moist Heat: Mechanism
- Sterilisation Methods: Filtration
- Chemical Methods
- Blood Spill Management
- Other Sterilisation Methods
- Testing of Disinfectant
- Spaulding Classification
Systemic Bacteriology
- Staphylococcaceae
- Staphylococcus Aureus
- Differential Diagnosis of Food Poisoning
- MRSA (Methicillin-Resistant Staphylococcus aureus)
- Coagulase-Negative Staphylococcus
- Streptococcaceae
- Streptococcus Agalactiae
- Streptococcus pneumoniae
- Neisseria
- Neisseria Meningitidis
- Neisseria Gonorrhoeae
- Gram Positive Bacilli:
- Volutin Granules
- Nocardia and Actinomycetes
- Actinomycetoma
- Actinomyces Israelii
- Bacillus Anthracis
- Clostridium
- Clostridium tetani
- C. Botulinum
- Clostridium Difficile
- Gram Positive Bacteria:
- Mycobacterium tuberculosis
- Microscopy
- Culture
- Typing methods
- Diagnosis of latent TB
- Non-photochromogens
- Mycobacterium leprae / Hansen’s bacillus
- Gram-Negative Bacteria:
- Strains (capable of causing diarrhoea)
- Laboratory diagnosis
- Shigella
- Different Shigella species
- Morganella
- Endemic Foci for Plague
- Enteric Fever
- Widal Test
- Culture Media
- Vibrio and Non-Fermenters:
- Differentiation between Classical and Eltor
- Pathogenesis
- Toxin
- Pseudomonas
- Burkholderia Pseudomallei
- Burkholderia Cepacia
- HBB (Hemophilus, Bordetella and Brucella):
- H.Influenzae
- H. Ducreyi
- Spirochetes:
- Treponema
- Tertiary Syphilis
- Leptospira
- Microscopy and Culture Media
- Rickettsiae:
- Organisms and Vectors
- Scrub Typhus
- Genus Coxiella
- Bartonella Henselae
- Chlamydia
Virology
- General Properties
- Symmetry (Genome)
- Structure
- Envelope
- Viral Replication
- Steps
- Classification
- Size of Viruses
- Shape & structure of viruses
- DNA Virus-Rules and Exception
- RNA Virus-Rules and Exceptions
- Genome size
- Virus Cultivation
- Inclusion Bodies (Cyto Pathic Effect)
- Assays: To know the Infectivity
- Interferons
DNA Virology
- Classification of Herpesviridae
- General Properties
- Herpes Simplex Virus 1 & 2
- Clinical features
- Lab diagnosis
- EBV: Epstein-Barr Virus (HHV4)
- Cytomegalovirus (HHV5)
- Human Herpesvirus 8 (HHV8)
- HPV (Human Pappilomavirus)
- Molluscum contagiosum
- Hepatitis A
- Hepatitis B (Dane Particle)
RNA Virus: Myxovirus
- Orthomyxovirus family
- Structure
- Pathogenesis
- Antigenic shift vs antigenic drift
- Lab diagnosis
- Measles virus
- Prodromal symptoms
- Complications
- Mumps
- Parainfluenza
RNA Virus: Picornaviridae
- Coxsackie
- Enterovirus
- Rhinovirus
RNA Virus: Rhabdoviridae
- Rabies
- Lab diagnosis
RNA Virus: Arbovirus
- ARB – Arthropod Borne
- Bunyaviridae
- Rubella Virus
- Japanese Encephalitis
- Yellow Fever
- Monkey Fever / Kyasanur Forest Disease
- Zika Flavivirus
- Dengue Virus
RNA Virus: Retrovirus
- Structure of HIV
- Structural Genes
- CDC AIDS case definition
- HTLV– 1
RNA Virus: COVID-19
- Structure and Pathogenesis
- RRTPCR – Real-Time Reverse Transcriptase PCR
Mycology
- Classification Based on Location
- Stains
- Culture
- Tinea Versicolor
- Tineasis – Clinical Aspect
- Dermatophytosis (Tineasis)
- Hair Perforation Test
- Mycetoma
- Chromoblastomycosis
- Penicillium marneffei
- Cryptococcus Neoformans vs Cryptococcus Gattii
- Types of Infections
- Candida Albicans – Laboratory Diagnosis
- Aspergillus Under Microscope
- Mucor / Zygomycetes / Glomeromycetes
- Pneumocystis Carinii
Parasitology
- Parasitology: Classification of Amoeba
- Parasitology: Flagellates
- Giardia Lamblia
- Trichomonas Vaginalis
- Parasitology: Hemoflagellates
- Trypanosoma Cruzi / South American Trypanosomiasis
- Leishmania Donovani
- Kala Azar
- Cutaneous Leishmaniasis
- Parasitology: Coccidian Parasites
- Toxoplasma Gondii
- Cryptosporidium
- Cylospora and Isospora
- Difference between Cryptosporidium, Cyclospora, and Isospora
- Haematozoa (Plasmodium and Babesia)
- Malaria
- Babesia
- Cestodes:
- Diphyllobothrium latum
- Tenia saginata and Tenia Solium
- Cysticercosis
- Echinococcus granulosus / Dog Tapeworm
- Hydatid cyst
- Echinococcus Multilocularis
- Hymenolepis Nana / Dwarf tapeworm
- Egg of H. nana
- Trematodes:
- Types of Trematodes
- Schistosomiasis/ Bilharziasis
- Paragonimus Westermani (Lung Fluke)
- Clonorchis Sinensis
- Fasciola Hepatica (Sheep liverfluke)
- Nematodes:
- Roundworm/Ascaris Lumbricoides
- Trichuris Trichiura/Whipworm
- Enterobius Vermicularis/Pinworm/Threadworm
- Strongyloides Stercoralis
- Life Cycle
Immunology
- Types of Immunity:
- Components of Innate Immunity
- Natural Killer Cells (NK Cells)
- Antibody-Dependent Cellular Cytotoxicity (ADCC)
- T Cells
- Interaction between B and T cells
- Difference Between MHC I and MHC II
- Types of T-cells
- Types of Hypersensitivity Reactions:
- Type I Hypersensitivity Mechanism
- Type II Hypersensitivity Mechanisms
- Type IV Hypersensitivity
- Immunity Tolerance Autoimmune Disorders:
- Systemic Lupus Erythematosus
- Scleroderma
- Myositis
- Immunodeficiency Disorders:
- Types of immunodeficiency
- Primary Immunodeficiency
- Defect in Lymphocyte maturation
- Defect in lymphocytic activation and function
- Systemic disease
- Transplant Immunology:
- Types of Grafts
- Transplant Rejection
- Graft Versus Host Disease
- Antigen and Antibody
- Antigen Antibody Reactions
Reading the above-mentioned microbiology key topics well in advance would certainly assist you in providing answers to most of the questions and would help you to emerge amongst the top rankers.
How to Prepare for NEET PG Microbiology?
NEET PG Microbiology preparation can be done strategically by following a systematic approach to preserve concept understanding, revision, and effective study practices. This is the guide to prepare for this high-yield topic well and score marks:
- Be Familiar with the Syllabus
The first and most important step towards NEET PG Microbiology preparation is being well aware of the syllabus. Study all the topics, as this helps you organise your study timetable in a better manner, and never skip any topic. Identify important topics that have high weightage in the exam.
- Study Approach – Antegrade vs. Retrograde
One of the common dilemmas students experience is deciding between the antegrade and retrograde approaches to learning.
- The antegrade approach involves learning topics step-by-step, from elementary to advanced concepts. It focuses on conceptualisation and comprehensive coverage.
- The retrograde approach begins with the learning of MCQs or current question papers and working backwards, which can lead to bypassing basic concepts.
While the antegrade approach is a slow process, it is strongly advised as it provides superior long-term retention and systematic learning over the retrograde approach, which usually compromises the clarity of concepts.
- Set Clear Goals
While preparing for NEET PG or any other entrance exam for postgraduate medical courses, goal-setting is inevitable. Hard work is not sufficient; smart work is what actually pays off. Fix realistic goals on a daily or weekly basis and follow up.
Focus on subject topics of higher weightage and don’t waste time on areas with a lower probability of questions. Remember that image-based questions are a significant component of NEET PG, and hence, take time to study and practice them properly.
- Repeatedly Revise
Revision is the key to success mantra of NEET PG preparations. Reading and not revising causes poor recall in the exam. Go through your notes and main points a couple of times before the exam. Plan ideally three or four revision cycles with sufficient time to consolidate your concepts. Research has established that continuous revision really improves ranking and retention.
- Test Yourself Regularly
Do not wait until the last week to gauge your knowledge. Periodic self-testing will make you pinpoint weak areas in time. Add the following to your daily study routine:
- Group discussions to compare understanding with peers.
- Daily recall sessions—spend the last two hours of your day revising what you learned.
- The 100 MCQ Rule: Practice solving at least 100 multiple-choice questions each day.
Consistent evaluation builds confidence and improves time management during the actual exam.
- Utilise the Last 100 Days
The last 100 days before NEET PG are the most important. Research indicates that almost 80% of your right answers in the test are from what you studied in the last 2–3 months. In these months:
- Try not to leave any subject untouched. Cover at least the main points of each.
- Try to work on solidifying your strong areas while going through weaker ones.
- Sleep enough, don’t stay up late nights prior to the exam, as drowsiness can lower productivity by as much as 10%.
- Master good time management and continue to fine-tune your revision schedule.
Time is your most valuable asset. Once lost, it can never be recovered.
FAQs about Microbiology Topics for NEET PG
- What are the key topics in Microbiology for NEET PG?
Special areas are bacterial cell wall, bacterial toxins, sterilisation methods, chemical disinfectants, and culture methods. In Bacteriology, special focus on the morphology, virulence, pathogenicity, and diagnosis of Staphylococcus, Streptococcus, Pneumococcus, Enterobacteriaceae, Vibrio, and Mycobacterium tuberculosis.
In Parasitology, life cycle and laboratory diagnosis of Ascaris, Trichuris, Enterobius, Echinococcus, Entamoeba, Giardia, Cryptosporidium, Plasmodium, Leishmania, Wuchereria, Taenia, Ancylostoma, and Toxoplasma.
- Is Microbiology significant in NEET PG?
Yes. Microbiology is a high-weightage topic in NEET PG, and 10–20 MCQs come every year. Proper subject knowledge can give you a better overall score and boost your rank tremendously.
- How do I study Microbiology online for MBBS or NEET PG?
You can select online structured microbiology courses or watch video lectures on YouTube or similar websites. Microbiology for UnderGrads by Dr. Apurba Sastry, Dr. Sandhya Bhat, and Dr. Deepashree R is highly recommended.
You can also join DocTutorials, where we offer comprehensive video lectures, concept-based, following the CBME (Competency-Based Medical Education) approach for better understanding and exam preparation.
- What is the best Microbiology textbook for MBBS students?
The best textbooks on Microbiology are:
- “Essentials of Medical Microbiology” by Dr. Apurba Sastry and Dr. Sandhya Bhat
- “Essentials of Medical Parasitology” by the same authors
Both books have crisp explanations, easy-to-understand pictures, and well-structured chapters, and thus are suitable for undergraduate as well as NEET PG studies.
- Which is the better method of studying Microbiology: Antegrade or Retrograde?
Antegrade is highly advised. It is a natural learning process, from basics to advanced concepts, to provide thorough coverage of the topic. The retrograde technique, primarily for MCQs or rapid overhauls, can neglect important conceptual blocks. Antegrade can be time-consuming, but it encourages better understanding and recall in exams.
Conclusion
Mastering microbiology for NEET PG requires a strategic blend of conceptual clarity, consistent revision, and smart practice. With concentration on high-yield topics, learning concept building blocks, and intermittent evaluation of how you are doing with MCQs, you can convert this tough subject into a scoring one.
For added support for NEET PG, DocTutorials has got you covered. Our comprehensive NEET PG course offers live interactive classes with hardcopy workbooks, high-yielding Qbank, and PYQ recall videos, exam-centric test series, and a special focus on INI-CET aspirants. We help medical students unlock their true academic potential and score excellently in the competitive exams.
Join DocTutorials today and explore our NEET PG course to excel in your medical journey!
Latest Blogs
-

INI CET Exam Pattern 2025: A Complete Guide with Subject-Wise Weightage
The Institute of National Importance Combined Entrance Test (INI CET) is your key to entering some of the most prestigious…
-

NEET PG Registration 2025: An Essential Guide For Exam Prep
The NEET PG registration, which is conducted online, is a crucial step in the exam process. Filling out the NEET…
-

NEET PG Syllabus 2026: A Must-Have Complete Guide for Exam Success
The NEET PG Syllabus acts as one of the foundation stones for aspiring postgraduate medical students like you who are…



